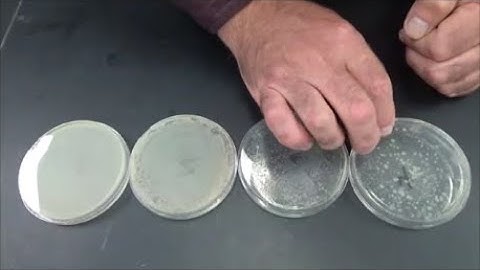
BIOL215L Lab 8 Serial Dilution and Enumeration

⬇ DOWNLOAD NOW
Kalau muncul iklan pop-up, tutup lalu klik tombol kembali
Download lagu Lab 8: Sort secara gratis hanya untuk keperluan promosi. Dukung artis favorit kamu dengan membeli musik original di iTunes atau platform resmi lainnya.
 CSE 130 - Lab 8: Sort Algorithm Demo
CSE 130 - Lab 8: Sort Algorithm Demo
 lab 8 sort py Visual Studio Code 2025 11 08 16 01 31
lab 8 sort py Visual Studio Code 2025 11 08 16 01 31
 Lab 8 Part 3 Sorting & Filtering
Lab 8 Part 3 Sorting & Filtering
 Data Structure Lab 8 : Sorting
Data Structure Lab 8 : Sorting
 Principles of Programming Chapter 8 Python Labs 8-1 and 8-2: Swapping Values and Using a Bubble Sort
Principles of Programming Chapter 8 Python Labs 8-1 and 8-2: Swapping Values and Using a Bubble Sort
 Principles of Programming Chapter 8, C++ Labs 8-1 and 8-2: Swapping Values and Using a Bubble Sort.
Principles of Programming Chapter 8, C++ Labs 8-1 and 8-2: Swapping Values and Using a Bubble Sort.
 फ्री की दवा - मोटापा, Pcod /Pcos.. #drrobin #facts #health #remedis #ayurved #doctor #remedy
फ्री की दवा - मोटापा, Pcod /Pcos.. #drrobin #facts #health #remedis #ayurved #doctor #remedy
BIOL215L Lab 8 Serial Dilution and Enumeration
BIOL215L Lab 8 Serial Dilution and Enumeration